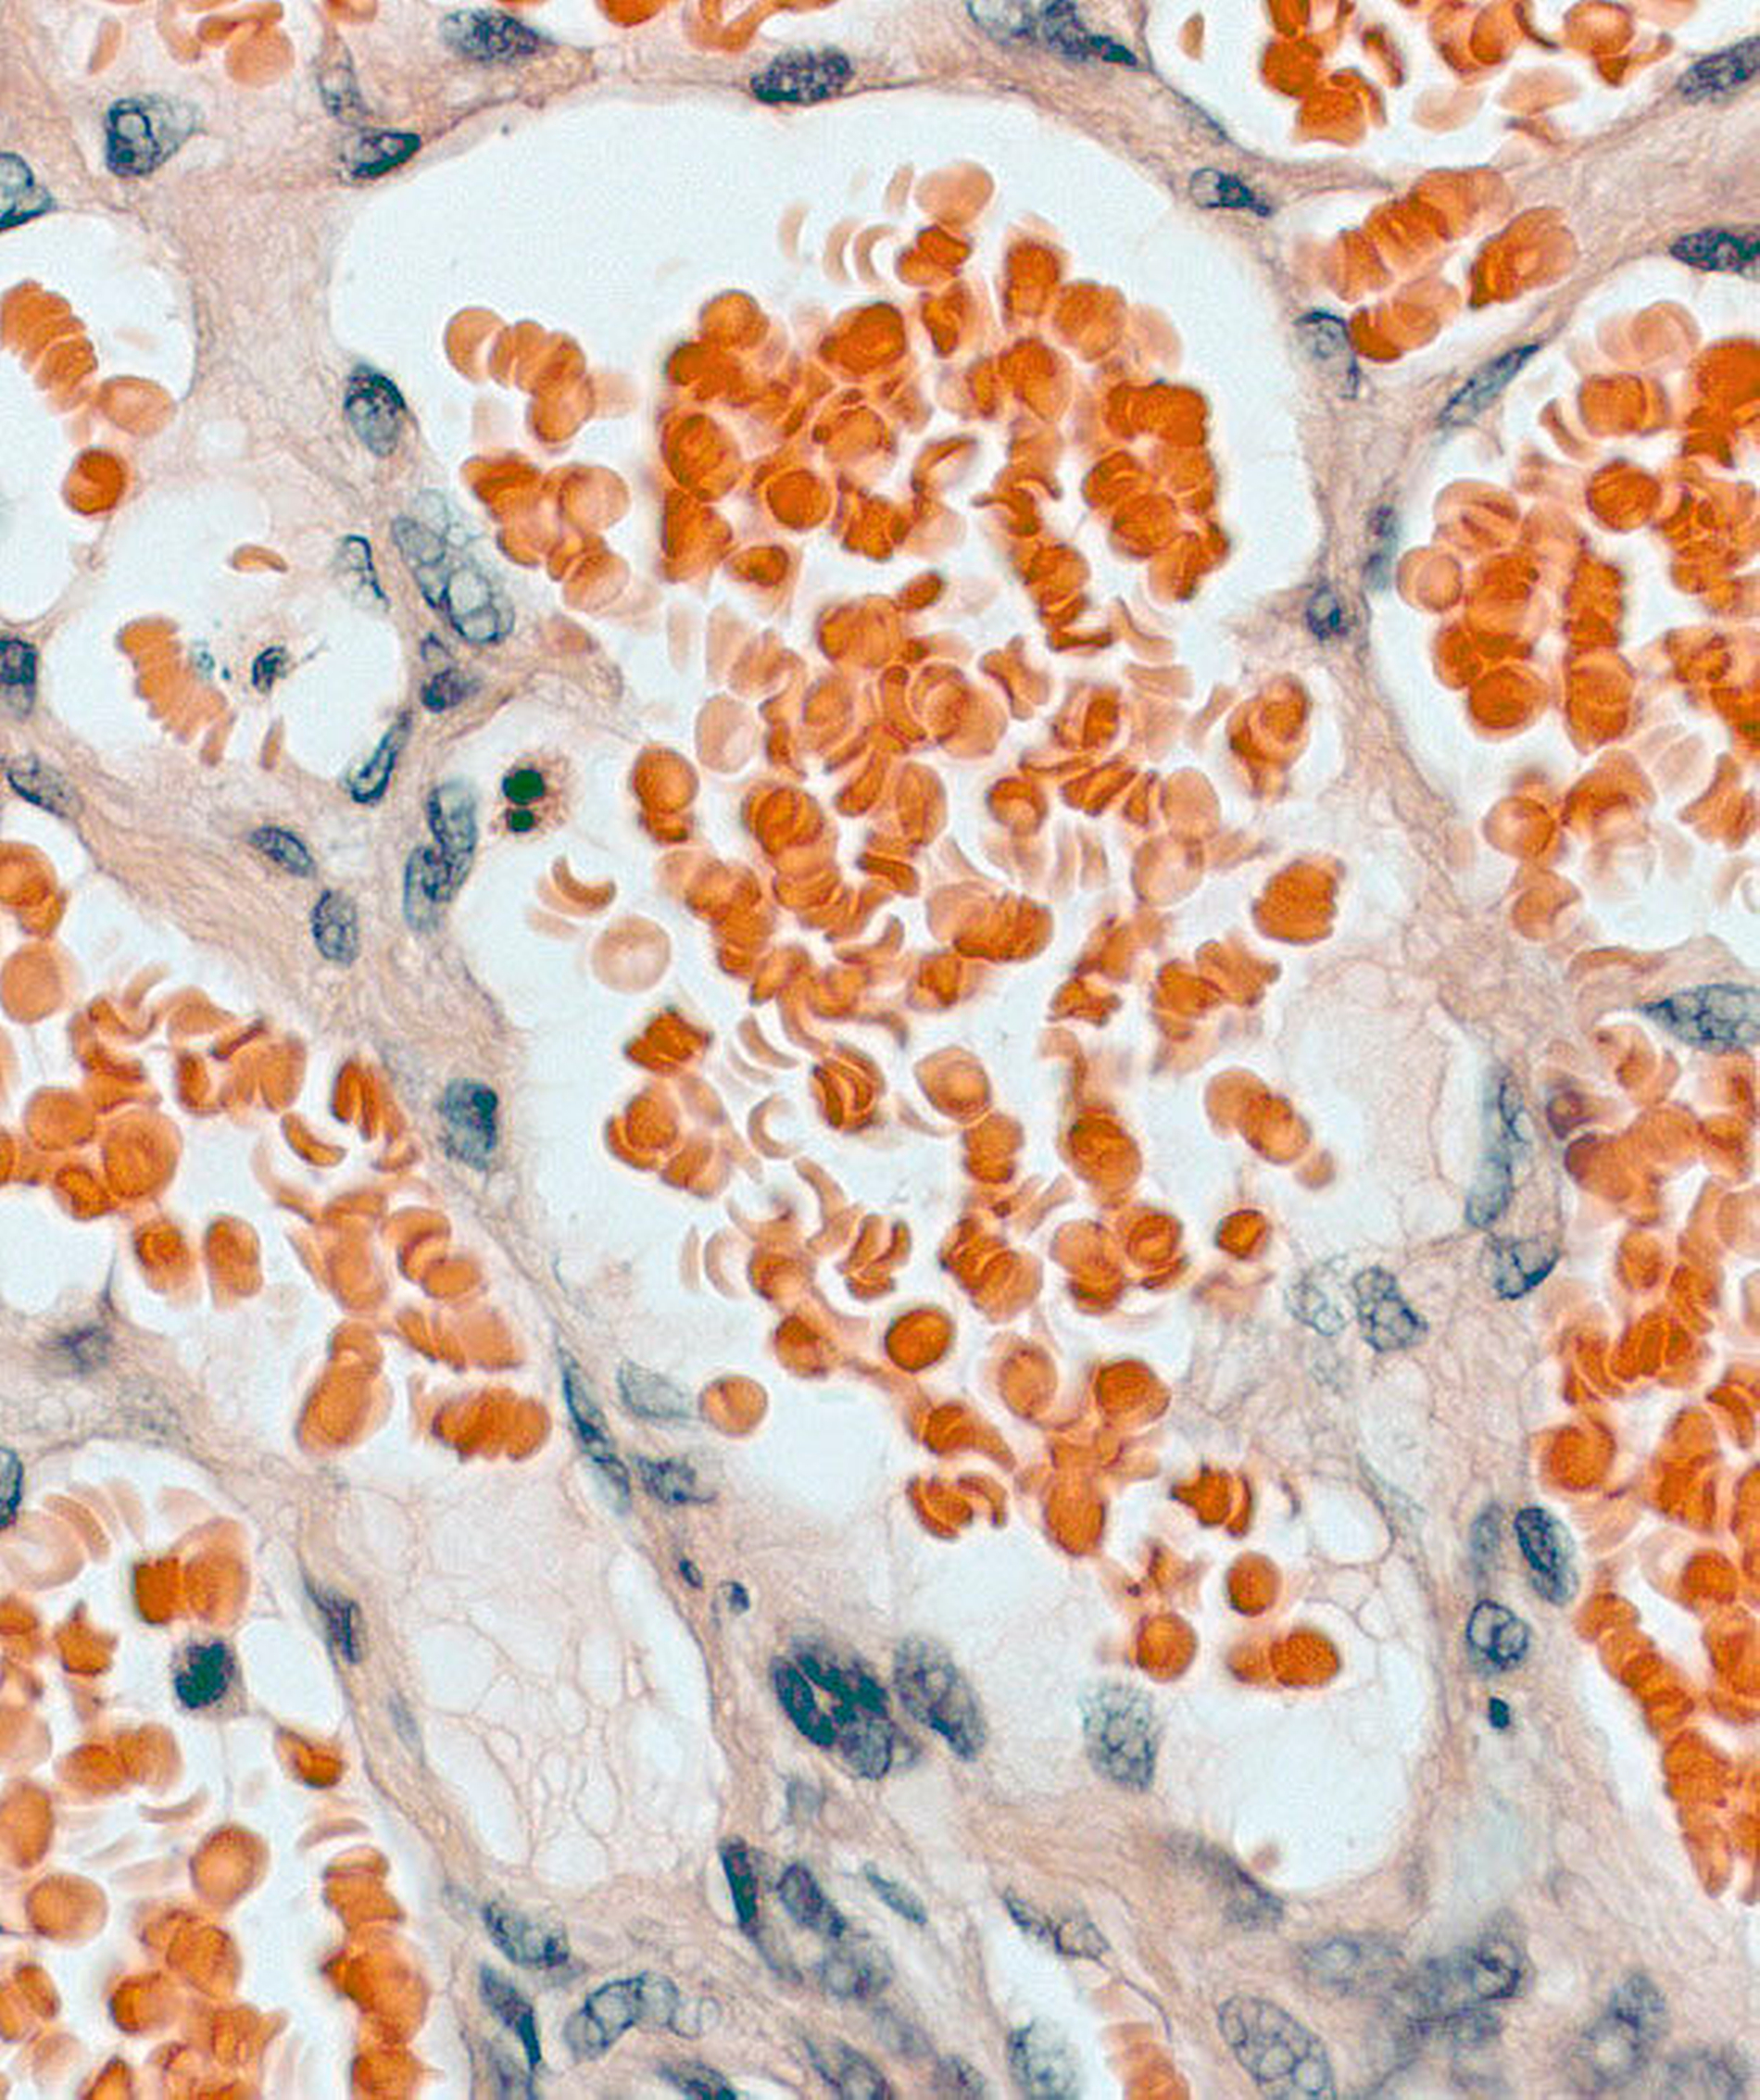

Hämangiom oder vaskuläre Malformation?
Ein 15-jähriger junger Mann stellte sich in Begleitung der Erziehungsberechtigten mit einer 1,5 cm x 2 cm großen, lividen, weich tastbaren und nicht druckdolenten Raumforderung der rechten Oberlippe (Abbildung 1) in der Poliklinik für Mund-, Kiefer- und Gesichtschirurgie der Universitätsmedizin Mainz vor. Er berichtete in Übereinstimmung mit seinen Eltern, dass diese schon seit seiner Geburt bestanden habe; dies konnte durch Fotos aus der Kindheit bestätigt werden, auf denen sich eine wenig ausgeprägte, bläuliche Verfärbung der Oberlippe präsentierte. An ein spezielles Trauma konnten sich der Patient und seine Eltern nicht erinnern. Allerdings sei es in den vergangenen zwei Jahren zu einer deutlichen Größenprogredienz gekommen. Da dies inzwischen zu ästhetischen und funktionalen Beeinträchtigungen führen würde, wurde nach einer Möglichkeit der Entfernung des Tumors gesucht.
Bei dem ansonsten völlig gesunden Patienten erfolgte zur Bestätigung der Diagnose eines Hämangioms / einer vaskulären Malformation eine Magnetresonanztomografie (MRT) mit Kontrastmittel. Hier zeigten sich zwei Läsionen an der Oberlippe rechts paramedian, die multiple in der T2-Wichtung hyperintense und in der T1-Wichtung muskeliso- bis gering hypointense Anteile aufwiesen. Es konnte eine Gefäßversorgung via Gefäßäste aus der A. labialis superior nachgewiesen werden (Abbildung 2). Unter der radiologisch bestätigten Vermutung, dass es sich um eine angeborene Fehlbildung des peripheren Gefäßsystems handelte, erfolgte die operative Entfernung desselben in einer ambulanten Intubationsnarkose (Abbildungen 3 bis 5). Beide Befunde wurden in toto ohne Sicherheitsabstand exstirpiert, wobei sich der kraniale Tumor unter dem M. obricularis oris befand, der nach Durchtrennung und Entfernung des Tumors durch entsprechende Nähte rekonstruiert wurde.
Die histopathologische Untersuchung des entnommenen Gewebes ergab ektatisch erweiterte venöse und wandstärkere arterielle Gefäße im Sinne einer vaskulären Malformation (Abbildung 6). In den Verlaufsuntersuchungen zeigte sich eine komplikationslose Wundheilung ohne Anhalt auf ein Rezidiv.
Diskussion
Sowohl Hämangiome als auch arteriovaskuläre Malformationen haben am häufigsten unbekannt-kongenitale Ursachen, sind also bereits im Säuglingsalter bei unterschiedlicher Ausprägung vorhanden. Hämangiome sind echte benigne, vaskuläre Neoplasien endothelialen Ursprungs mit einer ungefähren Inzidenz von drei bis fünf Prozent, die am häufigsten im Kopf- und Halsbereich und hier an den typischen Lokalisationen wie Parotisloge, Wange, Augenlider oder Stirn auftreten [Alves et al., 2006]. Selten können sie auch im Kieferknochen gefunden werden [Matheis und Kämmerer, 2018]. Im Gegensatz zu den Hämangiomen entstehen vaskuläre Malformationen durch eine fehlerhafte Morphogenese der betroffenen Gefäße [Werner et al., 2001]. Während die Entwicklung von echten Hämangiomen typischerweise die früheste Kindheit betrifft und in einem charakteristischen Lebenszyklus verläuft (initiale Proliferationsphase, Stagnationsphase und in einem erheblichen Teil der Fälle: Involutionsphase), zeigen vaskuläre Malformationen, wie im beschriebenen Fall, keine Involutions-, sondern vielmehr eine Progessionstendenz proportional zu dem Gesamtwachstum und/oder stimuliert durch hormonelle Umstellungen (zum Beispiel Pubertät oder Geburt) sowie Traumata [Ernemann et al., 2003; Kämmerer und Kunkel, 2008]. Größenveränderungen im Sinne einer Volumenzunahme auch nach dem Abschluss des Wachstumsalters ergeben sich bei vaskulären Malformationen, die in der Kopf- und Halsregion in ungefähr 0,1 Prozent der Bevölkerung auftreten [Han et al., 2015], vor allem passiv durch die Aufweitung der Gefäßlumina, da die zumeist hypoplastischen Gefäßwandstrukturen mit zunehmendem Lebensalter dem Perfusionsdruck nachgeben.
Die grundsätzliche Unterscheidung zwischen Hämangiomen und vaskulären Fehlbildungen hat vor allem Bedeutung für die Behandlungsstrategie. Während die Therapie eines Hämangioms bei nachgewiesener Wachstumstendenz sofort erfolgen sollte, kommen bei vaskulären Malformationen auch primär konservative Ansätze infrage. Somit ergibt sich die Indikation zur therapeutischen Intervention bei kleinen vaskulären Malformationen der Kopf- und Halsregion nicht, wie bei den Hämangiomen aus der Begrenzung des destruktiven Wachstums, sondern aus der Vorbeugung beziehungsweise der Therapie von passiven Gewebedeformierungen, der Prophylaxe von Blutungen oder aus der Notwendigkeit einer differenzialdiagnostischen Abgrenzung [Kämmerer et al., 2008]. Neben der klinischen Untersuchung können bildgebende Verfahren wie die Computertomografie oder die Magnetresonanztomografie, aber auch die Doppler-Sonografie zu einer verbesserten Darstellung der Ausdehnung oder Beschaffenheit der Läsion herangezogen werden [Robertson et al., 1999]. Therapeutisch besteht die Möglichkeit der Sklerosierung (zum Beispiel mit Ethanol), der Ligatur der versorgenden Gefäße, der Kürettage und schließlich, wie im beschriebenen Fall, der chirurgischen Resektion. Bei größeren Fehlbildungen des peripheren Gefäßsystems im Kopf- und Halsbereich ist eine Kombination aus endovaskulärer Embolisierung und chirurgischer Entfernung das Mittel der Wahl [Jafarian et al., 2016].
PD Dr. Dr. Peer W. Kämmerer, M.A., FEBOMFS
Leitender Oberarzt / Stellvertretender Klinikdirektor
Klinik und Poliklinik für Mund-, Kiefer- und Gesichtschirurgie – plastische Operationen der Universitätsmedizin Mainz
Augustusplatz 2
55131 Mainz
peer.kaemmerer@unimedizin-mainz.de
Fazit für die Praxis
Hinsichtlich der Zuordnung der vaskulären Läsionen im Kopf- und Halsbereich existiert immer noch eine erhebliche Unsicherheit; insbesondere Übergangsformen können nicht immer klassifiziert werden.
Hämangiome, als echte Neoplasien, wachsen schnell und destruktiv. Typischerweise kommt es im späteren Kindes- und frühen Jugendalter zu einer Involution.
Arteriovaskuläre Malformationen zeigen keine Rückbildung, sondern durch die passive Volumenzunahme eine Wachstumsprogredienz, die zu erheblichen ästhetischen und funktionellen Einschränkungen führen kann.
Literaturverzeichnis
1. Alves, S., Junqueira, J. L., de Oliveira, E. M., Pieri, S. S., de Magalhaes, M. H., Dos Santos Pinto, D., Jr. und Mantesso, A. (2006). „Condylar hemangioma: report of a case and review of the literature.“ Oral Surg Oral Med Oral Pathol Oral Radiol Endod 102(5): e23-27.
2. Matheis, P. und Kämmerer, P. W. (2018). „Besonderer Fall mit CME. Intraossäres Hämangiom des rechten Unterkiefers.“ Zahnärztliche Mitteilungen 108(9): 28-32.
3. Werner, J. A., Dunne, A. A., Folz, B. J., Rochels, R., Bien, S., Ramaswamy, A. und Lippert, B. M. (2001). „Current concepts in the classification, diagnosis and treatment of hemangiomas and vascular malformations of the head and neck.“ Eur Arch Otorhinolaryngol 258(3): 141-149.
4. Ernemann, U., Hoffmann, J., Grönewäller, E., Breuninger, H., Rebmann, H., Adam, C. und Reinert, S. (2003). „Hämangiome und vaskuläre Malformationen im Kopf-Hals Bereich.“ Radiologe 43: 958-966.
5. Kämmerer, P. W. und Kunkel, M. (2008). „Vaskuläre Malformation der Wange.“ Zahnärztliche Mitteilungen 98: 42-44.
6. Han, H. H., Choi, J. S., Seo, B. F., Moon, S. H., Oh, D. Y., Lee, H. G. und Rhie, J. W. (2015). „Successful treatment of posttraumatic arteriovenous malformation of the lower lip.“ J Craniofac Surg 26(3): e199-201.
7. Robertson, R. L., Robson, C. D., Barnes, P. D. und Burrows, P. E. (1999). „Head and neck vascular anomalies of childhood.“ Neuroimaging Clin N Am 9(1): 115-132.
8. Jafarian, M., Dehghani, N., Shams, S., Esmaeelinejad, M. und Aghdashi, F. (2016). „Comprehensive Treatment of Upper Lip Arteriovenous Malformation.“ J Maxillofac Oral Surg 15(3): 394-399.